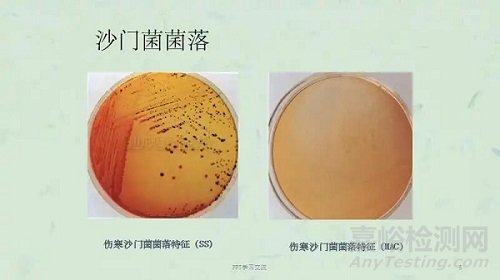
沙門菌屬微生物學檢查及鑒定

您當前的位置:檢測資訊 > 科研開發(fā)
嘉峪檢測網 2021-09-23 16:26
沙門菌屬體型大多為(0.7~1.5)μm×(2.0~5.0)μm,其無芽胞,是無莢膜的革蘭陰性直桿菌,除雞沙門菌外都有周身鞭毛,能運動,多數(shù)有菌毛。
培養(yǎng)特性
營養(yǎng)要求不高,在普通瓊脂培養(yǎng)上即能生長,在液體培養(yǎng)基中呈均勻混濁。在SS瓊脂和麥康凱瓊脂培養(yǎng)基上35℃~37℃ 24h可形成直徑約2~4mm的透明或半透明菌落,對膽鹽耐受。產H2S者在SS瓊脂上形成黑色中心。
生化反應
除亞利桑那菌沙門菌外均不能發(fā)酵乳糖,大多數(shù)IMViC試驗為-+-+,KIA:K/A、產氣+/-、H2S+/-,MIU:動力+、吲哚-、脲酶-.
抗原結構
主要由0抗原和H抗原組成,部分菌株有類似大腸桿菌K抗原的表面抗原,與細菌的毒力有關,故稱Vi抗原。
(1)0抗原:即菌體抗原。沙門菌屬的菌體抗原有58種,以阿拉伯數(shù)字依次標記:根據(jù)沙門菌有共同的O抗原這一特點,分類學者將有共同抗原的細菌歸為一組,這就使沙門菌分成42個群(或組)。即A、B、C……Z和O16~O67群。每群都有群特異性抗原,如A群O2、B群04、D群O9等。
(2)H抗原:即鞭毛抗原。H抗原是定型的依據(jù)。
沙門菌H抗原有兩相,第一相為特異性抗原,用a、b、c……表示;第二相為共同抗原,用1、2、3……表示。
(3)表面抗原:已證實沙門菌屬有Vi、M和5抗原三種。Vi抗原加熱60℃30min或經石炭酸處理被破壞,其存在時可阻止0抗原與相應抗體發(fā)生凝集。
變異性
(1)S-R變異,菌落光滑型經人工培養(yǎng)傳代后逐漸變成粗糙型。此時菌體表面的特異多糖抗原喪失,在生理鹽水中可出現(xiàn)自凝。
(2)H-O變異,指有鞭毛的沙門菌失去鞭毛的變異。
(3)相位變異,具有雙相H抗原(第I相為特異相,第Ⅱ相為非特異相)的沙門菌變成只有其中某一相H抗原的單相菌,稱相位變異。
(4)V-W變異,失去全部Vi抗原的變異。
致病性
致病因素有侵襲力、內毒素和腸毒素3種。臨床上可引起胃腸炎、腸熱癥、菌血癥或敗血癥等。其中腸熱癥屬法定傳染病。
1.腸熱癥:即傷寒與副傷寒病。由傷寒與副傷寒沙門菌所引起的慢性發(fā)熱癥狀。為法定傳染病之一。
2.食物中毒:引起食物中毒的沙門菌以鼠傷寒、腸炎、湯卜遜、豬霍亂、乙型及丙型副傷寒沙門菌為常見。
3.慢性腸炎:沙門菌可引起老人和兒童的慢性腸炎。
4.敗血癥:多由豬霍亂沙門菌引起。
5.沙門菌的局部感染。如頸部、腰部等。
微生物學檢查
檢查方法及鑒定
(1)不同標本的分離培養(yǎng)
1)糞便:一般將糞便或肛拭直接接種于SS和麥康凱平板上,用兩種培養(yǎng)基的目的是為提高標本的陽性檢出率。
2)血液和骨髓:抽取患者血液5ml或骨髓0.5ml,立即接種于含0.5%膽鹽肉湯或葡萄糖肉湯5ml試管中進行增菌,48h將培養(yǎng)物移種到血平板和腸道鑒別培養(yǎng)基上,若有細菌生長取菌涂片革蘭染色并報告結果。對增菌培養(yǎng)物連續(xù)培養(yǎng)7天,仍無細菌生長時,則報告陰性。
3)尿液:取尿液2~3ml經硫磺酸鹽肉湯增菌后,再接種于腸道菌選擇培養(yǎng)基或血平板上進行分離培養(yǎng),亦可將尿液離心沉淀物分離培養(yǎng)。
4)局部感染的膿液。
(2)鑒定
沙門菌屬的鑒定與志賀菌屬相同,須根據(jù)生化反應和血清學鑒定兩方面進行。
1)初步鑒定:如為革蘭陰性桿菌時作氧化酶試驗,陰性時,挑取可疑菌落分別移種于KIA和MIU上。并作生化反應。以沙門菌多價診斷血清作玻片凝集試驗。凡符合KIA:K/A、產氣+/-、H2S+/-、MIU:動力+、吲哚-、脲酶-,氧化酶-,觸酶+,硝酸鹽還原+,以沙門菌多價血清作玻片凝集試驗陽性,鑒定為沙門菌屬。
2)最后鑒定:沙門菌血清學鑒定主要借助于沙門菌O抗原多價血清與O、H、Vi抗原的單價因子血清。甲型副傷寒沙門菌、鼠傷寒沙門菌和傷寒沙門菌分別屬于A、B、D血清群。
(3)血清學診斷與分型
肥達試驗:肥達試驗是一種試管凝集反應。用已知的傷寒桿菌O、H抗原和甲、乙型副傷寒桿菌H抗原,與待測血清作試管或微孔板凝集實驗,以測定血清中有無相應抗體存在,作為傷寒、副傷寒診斷的參考。
分型
由于沙門菌95%屬于A-F群,所以先進行A-F多價O血清凝集,依據(jù)6個O因子血清分別定群,分為A群、B群、C1亞群、C2亞群、D群、E群、F群綜合H因子血清第一、第二組。依據(jù)凝集結果決定所屬血清型。
用生化反應鑒定為沙門菌后,需要進一步用分型血清進行分型。沙門菌的血清學分型在鑒定中有著關鍵的作用。分型應用成套的沙門菌因子血清做玻片凝集法,一般分三步進行:
①由于沙門菌95%屬于A-F群,所以先進行A-F多價O血清凝集,依據(jù)6個O因子血清分別定群:O2凝集者為A群,O4為B群,O7為C1亞群,O8為C2亞群,O9為D群,O3,10為E群,O11為F群。
屬于A-F各O群的常見菌型依次用下表所述H因子血清檢查第一相和第二相的H抗原

②如疑為沙門菌而A-F多價血清凝集陰性,應用Vi因子血清檢查;如凝集則將濃菌液隔水煮沸30分鐘以破壞Vi,再與A-F血清試驗而定群;如Vi凝集陰性可進一步用OC,OD,OE,OG多價血清鑒定。
③如是雙相菌,進一步用復合因子血清1,2,3,5;e,x,v;l,w檢查2相抗原(常見沙門菌的抗原結構一般在診斷血清試劑盒中有詳細介紹)。
沙門菌的預防
加強飲食衛(wèi)生,防止飲用污染食品及水源,攜帶者的積極治療,皮下注射死菌苗或口服減毒活菌苗也可預防沙門菌屬細菌的感染。臨床治療主要依據(jù)體外藥敏試驗結果來選用敏感的抗生素,保持水及電解質的平衡,對并發(fā)癥積極處理,如腸出血、腸穿孔、膽囊炎、心肌炎等。(對于傷寒沙門菌感染,可選擇的抗生素有氯霉素、氟喹諾酮類、氨芐西林、復方新諾明、三代頭孢等。)

來源:Internet